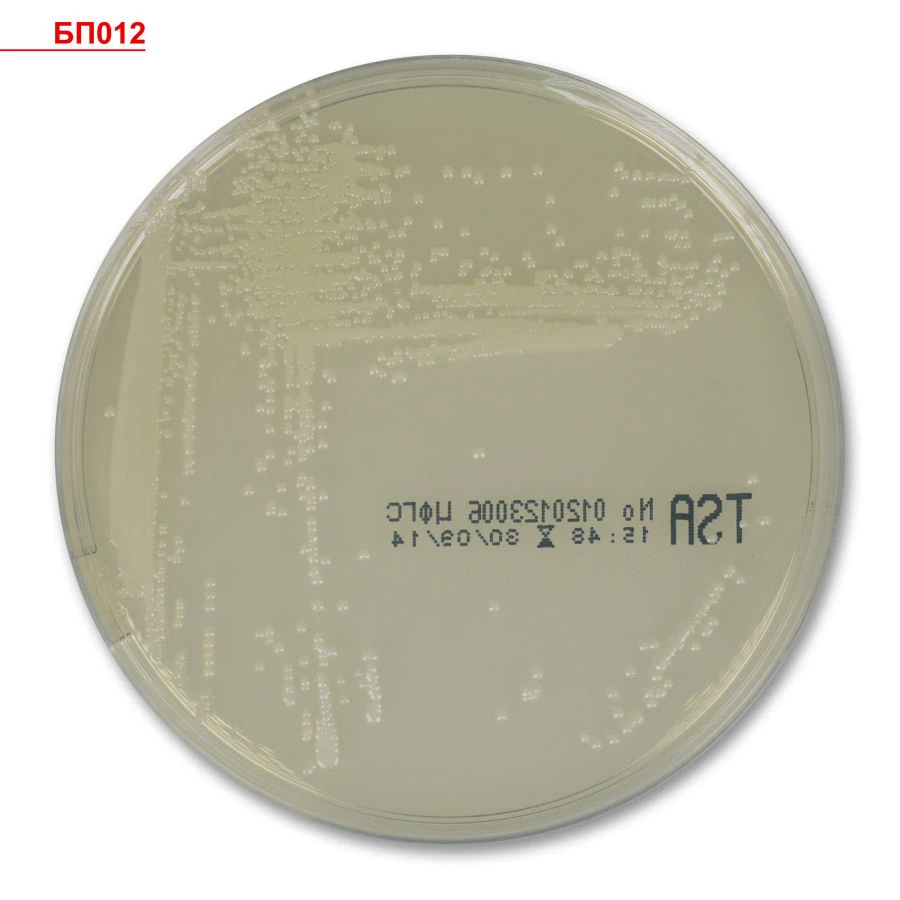
وسط أغار كولومبي جاهز للاستخدام لعزل البكتيريا إيجابية الجرام

متاح للاستيراد
متاح للاستيراد
وسط أغار كولومبي جاهز للاستخدام لعزل البكتيريا إيجابية الجرام وزراعتها
الشركة المصنعة:
ش.ذ.م.م "تسفغس
السعر:
طلب عرض سعر
أسعار الجملة متاحة
شروط FOB و CIF و EXW متاحة
الوصف
هذا ready-to-use microbial media مصنوع في روسيا ومتاح للاستيراد إلى الأسواق العالمية. المنتجات الروسية معروفة بمتانتها وموثوقيتها ونسبة السعر إلى الأداء الممتازة.
للحصول على مواصفات المنتج التفصيلية، يرجى الاطلاع على علامة تبويب المواصفات. اتصل بفريقنا لطلب معلومات الأسعار والتوافر والشحن.
شارك متطلباتك للحصول على رد سريع!
رد فوري خلال 15 دقيقة
أفضل أسعار الجملة مضمونة
مباشرة من الشركة المصنعة
التسليم والدفع
شروط الشحن
وقت التسليم
الشحن البحري: 30-60 يوم (حسب الوجهة)
الشحن الجوي: 14-21 يوم (للطلبات العاجلة)
طرق الدفع
منتجات مماثلة قد تهمك

وسط غذائي متعدد الاستخدامات من تريبتيكازو-صويا
عرض التفاصيل
وسط الشوكولاتة لعزل الميكروبات المتطلبة
عرض التفاصيل
وسط غذائي تشخيصي انتقائي مخصص للبكتيريا المعوية، جاهز للاستخدام، أغا
عرض التفاصيلموردون موثوقون
جميع المنتجات يتم الحصول عليها مباشرة من المصنعين الروس المعتمدين
ضمان الجودة
المنتجات تلبي معايير الجودة الدولية مع الشهادات المناسبة
الشحن العالمي
حلول لوجستية موثوقة لتوصيل المنتجات إلى موقعك
مدفوعات آمنة
خيارات دفع آمنة متعددة لتسهيل المعاملات الدولية